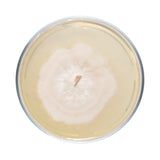
Image thumbnail: Culture Wine Cap Mushroom Agar Plate Culture

Wine Cap Mushroom Plate Culture
Plate Cultures are made to order. Current processing times are 3-4 weeks, depending on strain.
Plate cultures are ideal for growers looking to make master bags, inoculate grain, make liquid culture, or make more plates.
Our wine cap plates are made to order in our in-house lab using medical-grade petri dishes. If properly stored upon arrival, they have a shelf life of approximately 6 months. Wine cap plates should be stored in the refrigerator to maintain viability. Note that mycelium cultures require basic lab skills. Handle using sterile technique to prevent contamination.
For complete descriptions of available wine cap strains, click on the names below.
NSSRA1 - Winslow Wine Cap
Stropharia rugosoannulata. Cloned from a wine cap specimen that was naturalized on Winslow farm (an organic farm in Falmouth, Maine.) A prolific fruiter that tends to produce throughout the growing season. Can tolerate a wide variety of substrates.
NSSRA2 - WI Wine Cap
Cloned from a wine cap specimen that was naturalized in Wisconsin.
NSSRA3 - Radical Wine Cap
Cloned from a wine cap specimen obtained from Radical Mycology Convergence.
NSSRA4 - Mausum Wine Cap
Cloned from a wine cap specimen obtained from Mausum Valley Mushrooms.
Frequently Asked Questions